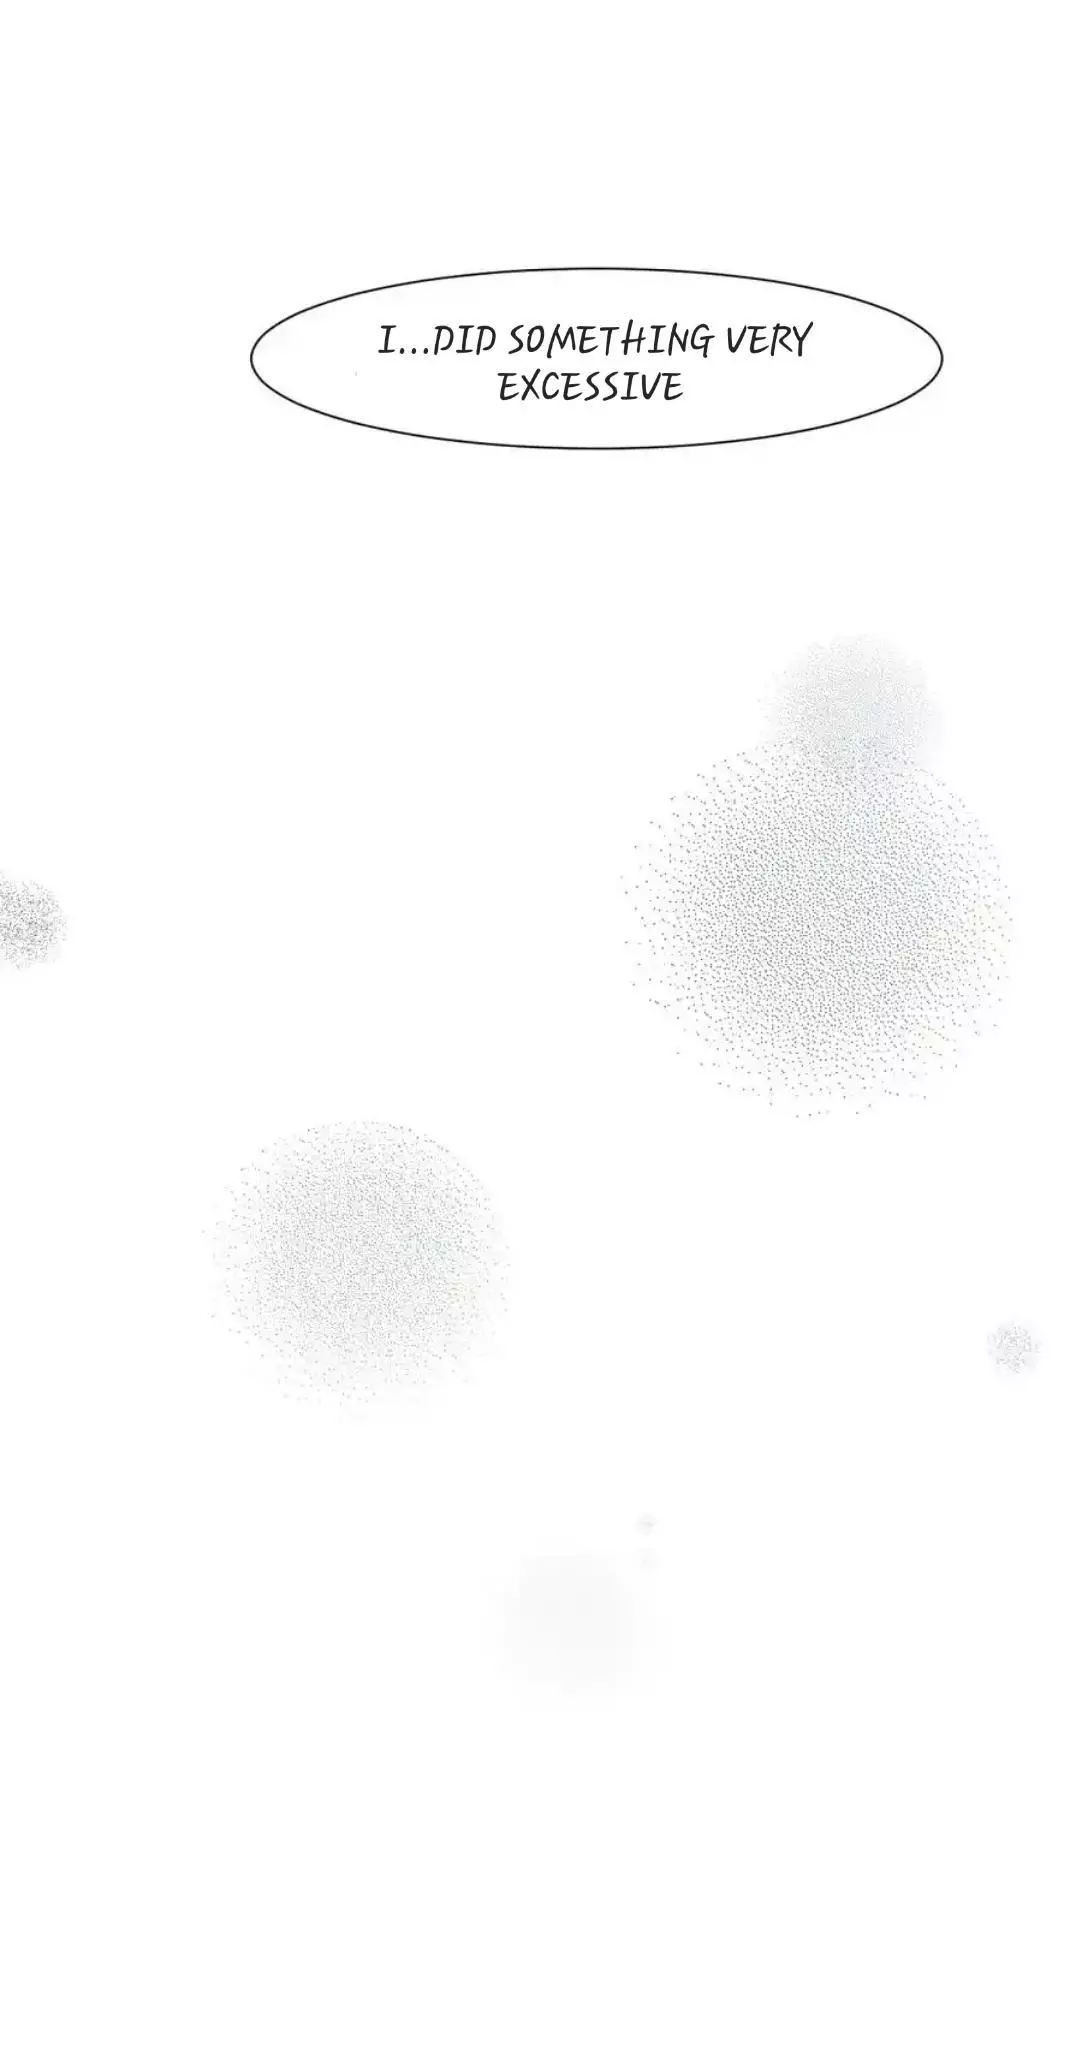

Prejudice - Chapter 26
Search
Popular Manga Ranking
Mr.A’s Farm
Chapter 17
October 4, 2025
Chapter 16
September 24, 2025
The Mating Of Elves
notice.
November 25, 2025
Chapter 56
November 7, 2025
Dog And Bird
Special.11 : Happily Ever After
January 24, 2026
Special.10 : Welcome Back
January 22, 2026
Painter of the Night
Chapter 131 Epilogue [The End]
January 10, 2025
Chapter 131
January 12, 2025
The Titan’s Bride 〘Official〙
Chapter 165
November 17, 2025
Chapter 164
November 17, 2025
Jinx
season.12 Episode..12
June 8, 2026
notice.100
May 22, 2026
The Hounds Of Sisyphus
Season 1 Finale
July 4, 2025
Creator's Note
July 12, 2025
Love Remedy [Official]
Chapter 35.5
May 6, 2025
Chapter 35
April 30, 2025
The Boundary Of Delusion
Extra. : Official Art
February 21, 2026
Extra. : Creator's Note
February 21, 2026
Scent And Sensibility
Creator's Note
September 7, 2025
Chapter 85.5
June 17, 2026

![Love Remedy [Official]](https://mangazizi.com/wp-content/uploads/2025/01/Love-Remedy-Official-75x106.jpg)


![Omega K’s Secret Love [18+ Official]](https://mangazizi.com/wp-content/uploads/2025/01/Omega-Ks-Secret-Love-18-Official-75x106.jpg)


